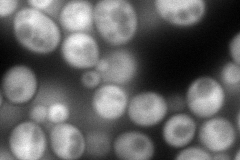
YMR315W
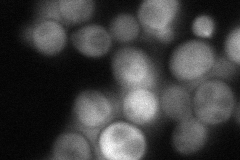
YMR315W
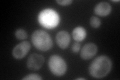
YMR315W

View description
Protein with NADP(H) oxidoreductase activity; transcription is regulated by Stb5p in response to NADPH depletion induced by diamide; promoter contains a putative Stb5p binding site
Localization:
Intensity:
Fold change:
Significance:
-
C’ GFP library in SD

cytosol84.03 -
N' NOP1pr-GFP in SD
cytosol241.337 -
N' TEF2pr-mCherry in SD

cell periphery,vacuole0 -
N' NATIVEpr-GFP in SD
cytosol72.2359 -
N' TEF2pr-VC and Cyto-VN in SD

#N/A0 -
C’ GFP library in SD+DTT

cytosol108.991.29No -
C’ GFP library in SD+H2O2

cytosol109.311.3No -
C’ GFP library in Starvation Media
cytosol275.853.28Yes -
C’ GFP library on the background of Pup2-DaMP

cytosol -
C’ GFP library on the background of CCT mutant

cytosol97.02651.15456No
